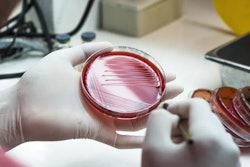

New News
Oct 9, 2019
List: Digitalization Companies From PACK EXPO
Looking for CPG-focused digital transformation solutions? Download our editor-curated list from PACK EXPO featuring top companies offering warehouse management, ERP, digital twin, and MES software with supply chain visibility and analytics capabilities—all tailored specifically for CPG operations.
Download Now
Sustainable Healthcare Packaging Solutions That Work
Industry leaders share proven strategies for reducing packaging emissions by up to 70% while meeting safety and regulatory requirements.
Read More
Downloads